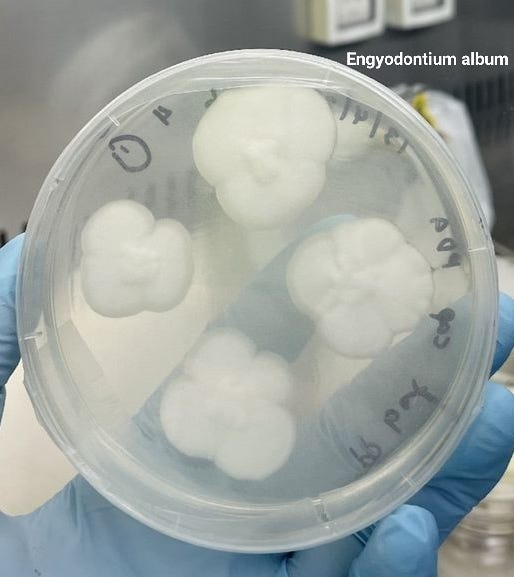

Plastic? No Problem
Focusing On Fungi That Like Eating Plastic
From Landfill to Plate: The Rise of Plastic-Eating Fungi
Having been inundated with statements about the hundreds of years it takes for plastics to degrade, all while leaching harmful chemicals like the Bisphenols which accumulate in our bodies—you’d think we'd have cut it out by now. But the reality is, plastic is everywhere. From landfills to the deepest oceanic trenches, to the products we use every day, this persistent material has woven itself into the fabric of our lives, and after producing over 8.3 billion tons of it since the 1960s [1], people are finally realizing that maybe plastic ain't so fantastic after all.
But what if there are solutions hiding in plain sight, solutions found in nature itself?
Enter the fascinating world of plastic-eating fungi – microscopic munchers with a mighty appetite for our “persistent” plastic problem.
These remarkable organisms, found in diverse environments from rainforests to the Great Pacific Garbage Patch, hold the solutions to completely change how we deal with plastic waste. These fungi use powerful enzymes to break down complex plastic polymers into simple sugars. As of today, over 430 species of fungi with an appetite for plastics have been discovered. Some even have preferences for certain plastics & with varying rates of consumption while others are more forgiving (will eat different types of plastic).
Here are a few promising contenders peckish for polymers that predate us & our petro-plastics:
Pestalotiopsis microspora: Originally identified in 1880 in fallen foliage of common ivy (Hedera helix) in Buenos Aires, it’s appetite for plastics was discovered in the Amazon rainforest in the 2010s isolated from plant stems in the Yasuni National Forest. This fungus tackles a range of plastics, including the notoriously durable polyurethane (PUR), polyethylene (PE), and polypropylene (PP) [2,3]. Even more impressive is its ability to thrive in both oxygen-rich and oxygen-poor environments, making it adaptable for various applications. Seeing as it is a cause of leaf spot in Hypericum patulum 'Hidcote' shrubs in Japan, one could potentially cultivate it & bypass the left on red tape. If you do, let me know 😎.

Aspergillus terreus and Engyodontium album: Their effect was discovered in 2023 This powerful duo specializes in breaking down polypropylene [3], a common plastic found in everything from food containers to textiles. PP accounts for roughly 28% of the world’s plastic waste and has a recycling rate of 1%. The researchers used Aspergillus terreus and Engyodontium album mushrooms to break down the material with success rates of 21% being “eaten” over 30 days of incubation, 25-27% over 90 days and completely broken down after 140 days. Currently, they require a little "head start" with UV light or heat treatment in a controlled setting to kickstart the degradation process, or in other words leave your PP in the sun for a bit before you feed it to Aspergi and Engyodon.
Parengyodontium album: This resilient fungus was found thriving in the plastic-laden environment of the Great Pacific Garbage Patch [4]. Its meal of choice? The ubiquitous polyethylene, which is used in all kinds of consumer goods [4]. This discovery highlights the potential for fungi based bioremediation efforts in marine environments without human supervision.
Oyster Mushrooms (Pleurotus ostreatus): These culinary favorites have talents beyond just being a nutritional powerhouse: they can decompose various plastics while remaining safe for human consumption! [5]. They will eat:
Polyethylene Terephthalate (PET): commonly used in plastic bottles and containers
Polyurethane: used in foam, adhesives, and coatings
Polyester: used in clothing, upholstery, and other textiles
Keep in mind that it will take ~ 1-2 months. Now imagine a future where at-home recycling systems produce both nutrient-rich compost and delicious edible mushrooms.
Aspergillus tubingensis: Discovered at a garbage dump in Islamabad, Pakistan. This fungus can break down polyurethane, a common industrial plastic. This it does in weeks instead of decades by secreting enzymes that degrade the plastic's chemical bonds.
The Science Behind the Magic: How Fungi Break Down Plastic
Fungi possess a unique arsenal of tools for breaking down complex materials. They release powerful enzymes, like cutinases and lipases, which act like molecular scissors, snipping apart the strong chemical bonds holding plastic polymers together. This process, known as biodegradation, breaks down the plastic into a form the fungi can consume.
Looking Ahead: A Future Where Fungi Lead the Way
While still in research and development like many things are kept, plastic-eating fungi hold immense promise for revolutionizing how we manage waste today. It's not hard to imagine a future where:
Landfills become a relic of the past: Fungi can be deployed in landfills to accelerate the decomposition of plastic waste, reducing our reliance on these environmentally problematic sites.
Oceans are cleansed of plastic pollution: Fungi-based bioremediation is already removing plastic debris from our oceans, protecting marine life and restoring delicate ecosystems.
Homes become mini-recycling centers: Imagine composting systems that utilize fungi to transform plastic waste into valuable resources like compost and edible mushrooms, closing the loop on our food systems. No plastic leaves the home!
Contaminated soil is renewed: Fungi can be used to remediate soil polluted with microplastics and other harmful chemicals, restoring land to health.
Biodegradable plastics become the norm: Scientists are exploring the use of fungal byproducts to create new types of biodegradable plastics, offering a sustainable alternative to conventional petroleum-based plastics.
Plastic-eating fungi represent yet another powerful example of nature's untapped potential to solve human-created problems. With determination & continued experimentation, these remarkable organisms can help undo past mistakes whilst building a healthier planet for generations to come.
Sources:
1. Geyer, R., Jambeck, J. R., & Law, K. L. (2017). Production, use, and fate of all plastics ever made. Science Advances, 3(7), e1700782.
2. Russell, J. R., Huang, J., Anand, P., Kucera, K., Sandoval, A. G., Dantzler, K. W., & Beckham, G. T. (2011). Biodegradation of polyester polyurethane by endophytic fungi. Applied and Environmental Microbiology, 77(17), 6076-6084.
3. Sadh, P. K., Duhan, S., & Duhan, J. S. (2018). Agro-industrial wastes and microbial enzymes mediated remediation of plastic contamination: A review. Environmental technology & innovation, 10, 126-134.
4. Romero-Garcia, S., Turner, G., Sánchez-Barrantes, S., Suárez-Merino, E., & Uresti-Rivera, E. E. (2020). Biodegradation of polyethylene microplastics by a novel marine strain, Rhodococcus sp. strain B7, isolated from plastic particles from the North Atlantic Ocean. Marine Pollution Bulletin, 158, 111443.
5. Sánchez, C. (2014). Cultivation of Pleurotus ostreatus and other edible mushrooms. In Mushrooms: Cultivation, nutritional value, medicinal effect, and environmental impact (pp. 75-100). CRC Press.







